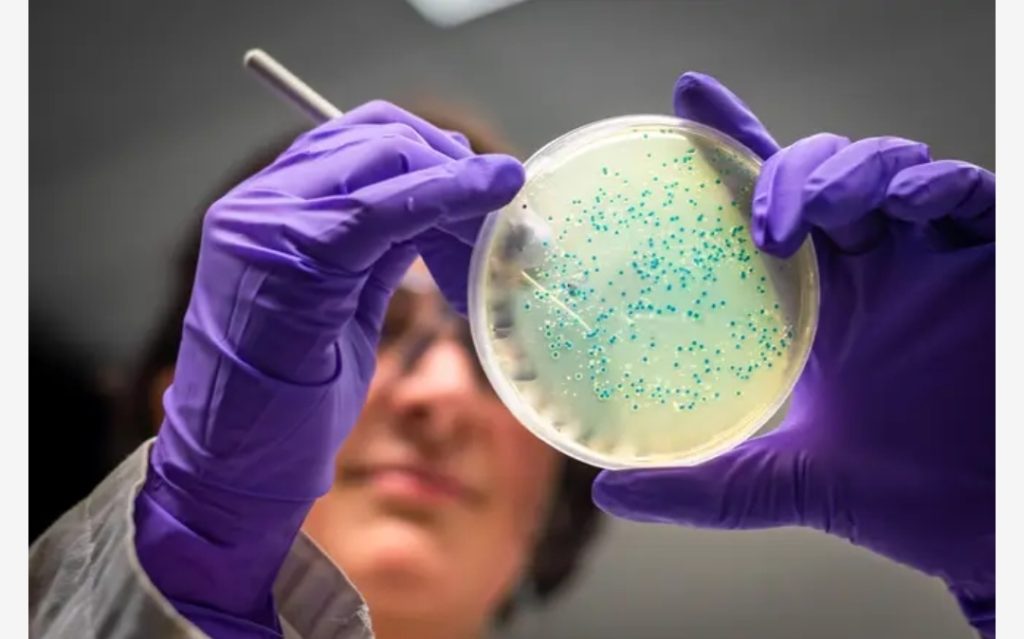

London, UK – A recent outbreak of an unusual strain of salmonella, Salmonella Saintpaul, has left five people hospitalised and 20 others ill across the United Kingdom, including 13 children. The UK Health Security Agency (UKHSA) is currently investigating the source of the infections, which began on February 20th.
Cases have been recorded nationwide, with six in the North West of England, four in the West Midlands, three in the South West, and two in the East of England. Single cases were reported in London, the East Midlands, the North East, and the South East. Beyond England, two cases each were confirmed in Northern Ireland and Wales, and one in Scotland.
The affected individuals range widely in age, from just one year old to 88, with a median age of 5. Sixteen of the patients are female, and nine are male. The UKHSA has noted that no new cases have been identified since March 2025.
This particular strain of Salmonella Saintpaul was previously linked to a 2023 outbreak that sickened 90 people after consuming contaminated cantaloupe melons. However, experts emphasize that there is no indication at present that cantaloupe is the cause of this unfolding outbreak.
Gauri Godbole, deputy director of gastrointestinal infections at the UKHSA, stressed the importance of hygiene in preventing further spread. “Gastrointestinal bacteria, such as Salmonella, can be spread from person to person as well as from food,” Godbole stated. “Anyone with diarrhoea or vomiting should wash their hands thoroughly after using the bathroom and avoid handling food or preparing food for others where possible.” She also advised against returning to work or sending unwell children to school or nursery until at least 48 hours after symptoms have cleared.
Salmonella is a common bacterial infection that causes food poisoning. Symptoms typically manifest within six to 72 hours of consuming contaminated food or water and can last for four to seven days. These include diarrhoea (which may be bloody in some cases), stomach cramps, fever, nausea, vomiting, headache, muscle aches, and a general feeling of unwellness (malaise). The bacteria are frequently found in raw or undercooked meat, poultry, eggs, unpasteurised milk, and occasionally on contaminated fruits and vegetables.
The UKHSA continues its investigations to pinpoint the exact source of this recent outbreak and prevent future occurrences.
Do you want to advertise with us?
Do you need publicity for a product, service, or event?
Contact us on WhatsApp +2348033617468, +234 816 612 1513, +234 703 010 7174
or Email: validviewnetwork@gmail.com
CLICK TO JOIN OUR WHATSAPP GROUP


